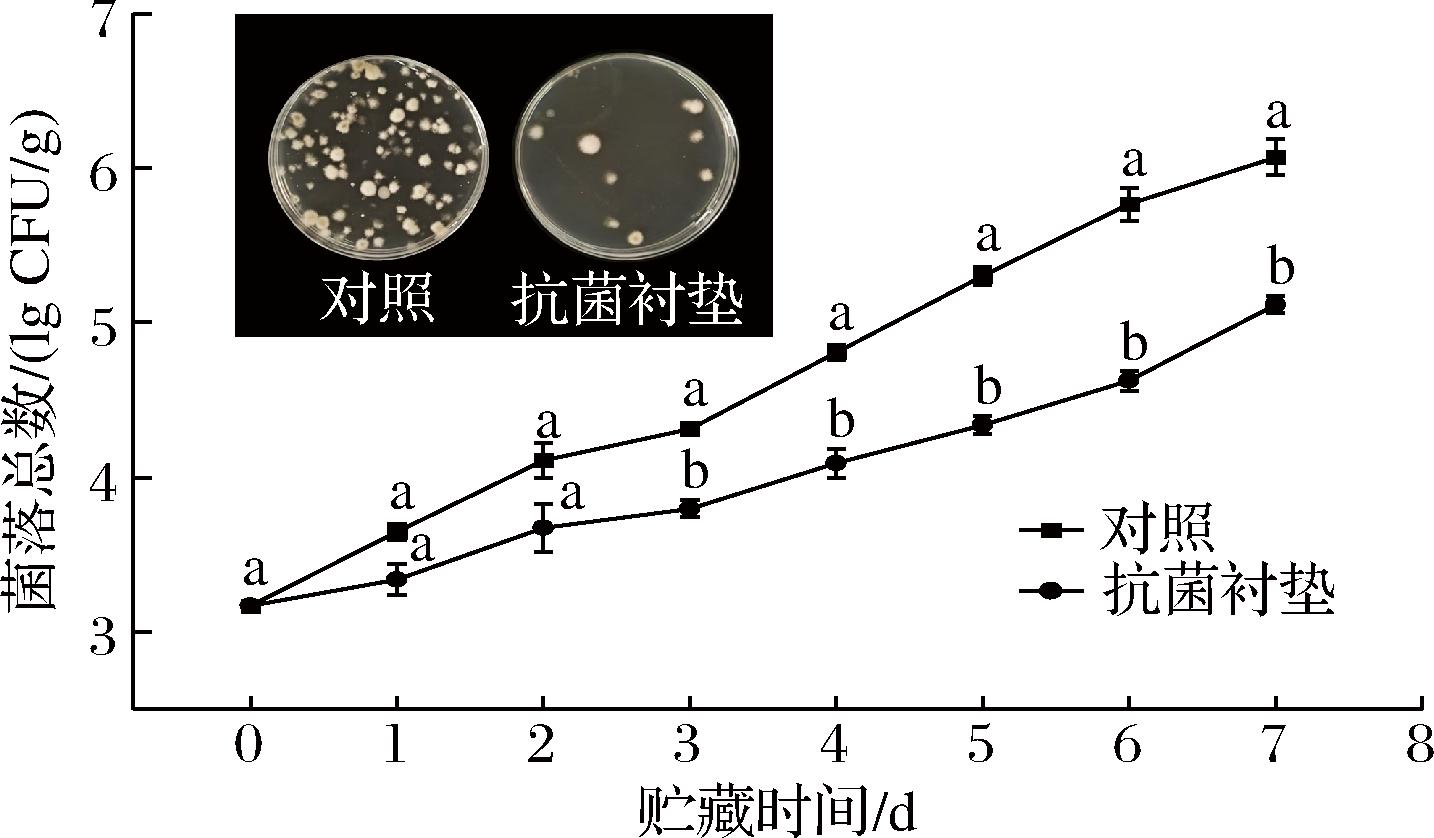

阳光玫瑰葡萄风味独特、果实饱满、营养价值高,由于其果皮较薄,在采摘和运输过程中会对葡萄果实造成机械损伤,增加其被空气中细菌和霉菌污染的风险。同时,阳光玫瑰葡萄的含水量及含糖量较高,采摘后生理代谢仍比较活跃,运输期间很容易发生褐变、硬度衰减和腐烂变质等现象,不仅降低果实商品价值,还存在危害消费者健康的潜在风险[1-2]。
果蔬农产品具有时令性、地域性,并有贮藏时间短、产销分离等特点,物流是实现其商品价值的关键环节[3]。为降低果蔬农产品的物流损耗率,运输中大多使用石油基塑料泡沫进行防护,然而其微塑料迁移问题尚未得到有效解决[4]。针对果蔬贮藏时间短的问题,运输中常采用化学、低温、气调等方法相结合,其中通常使用衬垫来满足抗压减振、防潮防湿的需求[5]。在葡萄保鲜领域,常采用采后表面消毒和气体熏蒸来延长货架期[6],但其效果维持时间有限;为在运输过程中保证葡萄新鲜度,通常使用复合型冷链运输[7],利用低温及抗菌物质协同减弱微生物繁殖对葡萄品质的影响,但由此产生了新的食品安全问题,使得研究者不断寻找更加安全绿色高效的果蔬保鲜方法。植物抑菌剂作为一种天然提取物,在保证食品安全的同时,通过扰乱细菌酶的合成与活性、破坏细胞壁和细胞膜结构等途径诱导细菌功能障碍,进而实现抑菌效果[8]。吕明珠等[9]研究发现红提葡萄经1%肉桂精油处理后结合低温高湿环境能够有效延长贮藏时间,证明了植物精油对葡萄的有效抑菌效果。葛耀进[10]研究发现在乳液油相中加入40%百里香酚能够在15 d内有效地保鲜猪肉,证明百里香酚在乳液中能够作为抑菌剂发挥良好的抑菌作用。目前植物抑菌剂通常作为保鲜液直接对果蔬农产品进行喷涂、浸渍和熏蒸处理,然而这种直接接触的处理方式会引起果蔬表面不均匀的褐变。本研究基于Pickering理论制备生物质抗菌泡沫衬垫,利用不同尺寸的纤维素构建三维网络结构,在确保力学强度的基础上应用Pickering理论均匀负载30 g/L的纳米化百里香酚乳液,并探究该衬垫在贮运过程中对阳光玫瑰葡萄的力学及生化防护效果。该设计结合泡沫衬垫的缓冲功能与百里香酚的非接触式抗菌功能,建立“物理防护-气相抑菌”双重保鲜机制,同步满足机械防护与微环境调控需求。
1 材料与方法
1.1 材料与试剂
阳光玫瑰葡萄,无锡市滨湖区天惠超市;百里香酚(98%),中国上海阿拉丁生化技术公司;单月桂甘油酸酯,广东聚百味食品配料有限公司;漂白硫酸盐针叶木浆(绝干浆),大连扬润贸易有限公司(中国);羧基化纳米纤维素,实验室制备;实验中所用的水均为去离子水,电导率小于20 μm/cm。
1.2 仪器与设备
S25实验室高剪切均质分散乳化机,上海鑫鲨机械设备有限公司;LC-JY92-IIDN超声细胞破碎仪,上海力辰邦西仪器科技有限公司;CR-400色度计,柯尼卡美能达光学仪器(上海)有限公司;GY-5B数显水果硬度计,艾普计量仪器有限公司;SN-HT手持式糖度计,上海尚仪仪器设备有限公司。
1.3 实验方法
1.3.1 材料与处理
随机选取3串不同葡萄梗上色泽新鲜、无机械损伤的阳光玫瑰葡萄,用无菌纱布拭去果实表面灰尘后放入盒底铺有不同衬垫的包装盒内,每组葡萄(300±20) g,衬垫厚度均为2 cm。将分装好的样品置于不同人工气候箱,条件设置为温度5 ℃、相对湿度90%,每隔1 d取样测定。
1.3.2 百里香酚乳液制备
将百里香酚和单月桂甘油酸酯以4∶6的质量比在60 ℃下共同加热搅拌5 min,形成均匀的共晶溶剂作为乳液油相。将酪蛋白酸钠溶解在pH 6.5的磷酸盐缓冲液中,形成2%的乳化剂水溶液作为乳液水相。在百里香酚乳液中总油相浓度为6%的条件下,将油相与水相混合并用剪切均质机处理5 min对溶液进行乳化。利用超声细胞破碎仪将乳液纳米化,设备功率设置为900 W,处理30 min。
1.3.3 抗菌衬垫制备
将打浆度为60 °SR的木质纤维以质量浓度20 g/L均匀地分散在去离子水中,并加入质量浓度5 g/L的羧基化纳米纤维素和质量浓度30 g/L的百里香酚纳米乳液混匀,其中木质纤维作为发泡材料骨架,纳米纤维素作为泡沫稳定剂,百里香酚乳液作为抗菌剂。向混合均匀的悬浮液中加入质量浓度为0.5 g/L的十二烷基硫酸钠溶液,在转速为2 000 r/min的悬臂搅拌器下发泡15 min,得到具有一定空气含量的湿泡沫,将其注入布氏漏斗中成型并在电热鼓风干燥箱中干燥固化制得纤维基发泡材料。
1.3.4 抗菌衬垫材料微观形貌
样品喷金处理后,采用钨灯丝扫描电子显微镜在高压真空模式下进行二次电子成像模式观察衬垫的微观形貌结构。
1.3.5 抗菌衬垫材料强度及防护性能
参考GB/T 4857.2—2005《包装 运输包装件基本试验 第2部分:温湿度调节处理》对抗菌衬垫进行不同温湿度的预处理;参考GB/T 8813—2020《硬质泡沫塑料 压缩性能测定》使用万能材料试验机对抗菌衬垫进行静态压缩性能测试,并记录应力-应变曲线得到抗菌衬垫力学性能;参考GB/T 4857.5—1992《包装 运输包装件 跌落试验方法》略作修改,在瓦楞纸箱中放入(300±20) g葡萄样品,将厚度为2 cm的衬垫置于葡萄样品与纸箱各内表面之间,使用跌落试验台测试抗菌衬垫对葡萄的跌落防护效果;参考GB/T 4857.23—2021《包装 运输包装件基本试验 第23部分:垂直随机振动试验方法(含勘误说明)》,运用上述包装方式,使用振动试验台测试抗菌衬垫对葡萄的振动防护效果。
1.3.6 菌落总数测定
参考GB 4789.2—2022《食品安全国家标准 食品微生物学检验 菌落总数测定》略作修改,取50 g样品放入无菌均质袋中,用拍击式均质器拍打5 min制成匀浆。使用无菌生理盐水制备系列稀释液并接种在对应培养基上,将其在37 ℃下孵育48 h以测定菌落总数,微生物数量表示为lg CFU/g。
1.3.7 阳光玫瑰葡萄品质指标测定
1.3.7.1 色差、褐变指数
随机选取不同葡萄梗上的葡萄各3枚,用色差仪测定阳光玫瑰的L*、a*、b*值。阳光玫瑰葡萄色泽用总色差(ΔE)来表征,褐变程度用褐变指数(browning index,BI)来表征。ΔE[11]和BI[12]的计算方式如公式(1)和公式(2)、公式(3)所示:
(1)
(2)
(3)
式中:L*、a*和b*值表示测定样品的色泽值;L0*、a0*和 b0*值表示新鲜样品色泽值。
1.3.7.2 失重率
分别测定第0天时各个包装内阳光玫瑰葡萄的质量,记为m0,测定贮藏时阳光玫瑰葡萄的质量m1,按照公式(4)计算样品失重率:
失重率![]()
(4)
1.3.7.3 果肉硬度
采用数显水果硬度计测定,探头直径为5 mm。随机选取不同葡萄梗上的葡萄各3枚,揭去果皮,测量结果取平均值。
1.3.7.4 可溶性固形物(total soluble solids,TSS)
使用手持式糖度计测量[13],随机选取不同葡萄梗上的葡萄各3枚,揭去果皮后放入研钵中磨碎,过滤后取汁液测定。
1.3.7.5 可滴定酸(titratable acidity,TA)
参照《果蔬采后生理生化实验指导》[14]进行实际结果测定。
1.4 数据处理
所有实验均为3次重复随机实验,数据采用SPSS软件进行显著性分析,P<0.05表示差异显著,采用Excel及Origin软件绘图。
2 结果与分析
2.1 抗菌衬垫对阳光玫瑰葡萄的力学防护性能
在衬垫的制备过程中,应用Pickering原理将纳米纤维素作为稳定剂吸附于泡沫空腔边界和节点处,使其形成稳定的胶体网络[15-17],从而能够令这种复杂的流体转化为轻质和坚固的结构,以减少葡萄在运输贮藏过程中受到的机械损伤。利用同样的原理,将百里香酚乳液处理到纳米级别并使其稳定均匀地吸附在材料上,制备具有抗菌功能的防护衬垫。
图1-a展示了抗菌衬垫的微观形貌,经过泡孔调控的衬垫材料呈现纤维网络紧密交织形态,其表面均匀附着百里香酚乳液。由图1-b可以看出,抗菌衬垫表面均匀密实,低密度与高孔隙率使其能够高效负载抗菌成分,同时具有轻质高强度的特点。图2显示出添加抗菌成分对衬垫力学性能的影响,并反映了高湿贮运条件对衬垫能量吸收值的影响,以及发生跌落和振动时衬垫对葡萄的防护作用。通过显著性分析可以看出,加入抗菌乳液令材料吸能值下降,但其影响并不显著,衬垫仍然保持412.69 kJ/m3的吸能值。当抗菌衬垫由常湿环境到高湿环境,纤维在遇到水分后损失部分弹性,吸能值下降至343.52 kJ/m3。在不同运输情况下,使用衬垫后的样品坏果率均有大幅度下降,即使在1.5 m角跌落的严苛跌落条件下,坏果率也保持在20%以内。这些结果表明衬垫在不同的运输环境下均能在承受载荷时展现出更卓越的能量吸收能力,并在受到冲击或振动时对葡萄表现可靠的物理防护效果。

a-微观形貌;b-物理特性
图1 抗菌衬垫的微观形貌与物理特性
Fig.1 Microscopic morphology and physical properties of antimicrobial liner

图2 衬垫在不同运输情况下对阳光玫瑰葡萄的防护效果
Fig.2 Effectiveness of the liner on protecting of Shine Muscat under different transportation situations
注:不同字母表示差异显著(P<0.05),以大小写区分因变量不同的数据(图3~图8同)。
2.2 抗菌衬垫对阳光玫瑰葡萄的抑菌效果
百里香酚乳液具有良好的广谱抗菌性,能够通过抑制细菌细胞生物膜形成并破坏成熟生物膜来抑制微生物生长,从而达到对葡萄的保鲜作用[18-20]。水果贮藏过程中菌落总数的大小是评估微生物污染程度的重要指标,对于水果来说,当菌落总数≤6 lg CFU/g时被认为是可食用的[21]。图3反映了阳光玫瑰葡萄在贮藏过程中菌落总数的变化情况。初始菌落总数为3.17 lg CFU/g,随着贮藏时间的推移,所有样品均显示出明显上升趋势,这是由于葡萄丰富的水分和糖分为微生物的生长和繁殖提供了有利条件[22]。然而数据表明,使用抗菌衬垫的样品在贮藏期内的菌落总数明显低于对照组(对照组)。在贮藏的前3 d,2组样品的菌落数量均保持在4.11 lg CFU/g以下,处于微生物生长的延滞期[23]。在第3天后,实验组菌落总数仍维持在较低水平,而对照组的菌落数量则迅速增加,在贮藏第6天和第7天时分别达到5.77、6.07 lg CFU/g,已超过可食用食品的最大限度,而第7天时实验组菌落总数为5.12 lg CFU/g,较对照组降低15.65%。结果表明,使用添加百里香酚乳液的抗菌衬垫能够有效抑制葡萄中微生物的生长,从而保持葡萄新鲜度。
图3 不同衬垫对阳光玫瑰葡萄贮藏期间菌落总数的影响
Fig.3 Effect of different liners on the total viable count of Shine Muscat during storage
2.3 抗菌衬垫对阳光玫瑰葡萄贮藏期间褐变的影响
褐变是阳光玫瑰葡萄贮藏过程中极易发生的品质劣化现象,葡萄的色泽直接影响了其商品价值和流通周期。如图4-a所示,新鲜葡萄呈现出饱满的黄绿色,随着贮藏时间延长,果实颜色逐渐加深并出现非原生的褐变斑点;在第6天时,对照组样品发生严重的褐变并伴随果梗脱落,实验组果实颜色加深,轻微出现褐变。在实验期间,含有抗菌衬垫的样品视觉效果显著优于对照组。

a-外观;b-ΔE与BI
图4 不同衬垫对阳光玫瑰葡萄贮藏期间外观、ΔE与BI的影响
Fig.4 Effect of different liners on appearance,ΔE,and BI of Shine Muscat during storage
任何颜色都有唯一的坐标值,可以通过该值计算出果实颜色的ΔE,从而反映出贮藏期间阳光玫瑰葡萄色泽的变化程度[24]。由图4-b可知,贮藏期间实验组的ΔE始终低于对照组。在贮藏的前3 d,2组样品的ΔE增速平缓,但第3天后对照组样品的ΔE值急剧上升,第7天时达到61.43,而同时实验组样品的ΔE值为57.34。BI可以反映葡萄的褐变程度,图中可以看出,样品BI的变化趋势与ΔE大致相同,但由于样品颜色的L*值、a*值和b*值的差异性变化,其BI值变化与ΔE略有差异,在贮藏第7天时,对照组样品的褐变程度为23.16,较实验组(18.79)升高23.26%。上述数据表明使用抗菌衬垫能够有效延缓阳光玫瑰葡萄的褐变,保持葡萄的色泽。这可能是由于抗菌处理能够延缓微生物的增长,减少氧化反应的发生,从而减缓褐变反应。同时,抗菌处理还可能通过减少果实表面的水分蒸发,降低果肉与空气的接触,进一步减缓了色泽变化。
2.4 抗菌衬垫对阳光玫瑰葡萄贮藏期间失重率的影响
果蔬采后失重主要是由呼吸代谢消耗和蒸腾作用造成的,阳光玫瑰葡萄作为一种含水量较高的水果,在贮藏过程中极易发生水分流失的情况,影响葡萄品质[1]。如图5所示,所有样品失重率均随贮藏时间增长,含有抗菌衬垫的样品的失重率始终显著低于对照组,从第4天开始出现较强的重量损失,在第7天时对照组失重率达到6.62%,实验组失重率为5.29%,降幅达20.1%。这与葡萄果实的水分蒸发和代谢过程相关,抗菌处理组在一定程度上减缓了水分流失,保持了果实的水分含量。与此同时,阳光玫瑰葡萄中的糖在贮藏过程中也容易发生分解,使其在贮藏期间的重量下降,但抗菌衬垫可以减缓这种损耗,使样品保持较低的失重率。

图5 不同衬垫对阳光玫瑰葡萄贮藏期间失重率的影响
Fig.5 Effect of different liners on the rate of weight loss of Shine Muscat during storage
2.5 抗菌衬垫对阳光玫瑰葡萄贮藏期间果肉硬度的影响
果粒的硬度是反映果实耐贮特性的重要指标,由图6可以看出,实验组样品的硬度下降幅度较对照组缓慢,且在整个贮藏过程中始终保持在较高水平。贮藏的前2 d,2组样品的硬度差异未达到显著水平,这与贮藏初期微生物增殖和失重率的变化相符。随着贮藏时间的延长,果粒硬度逐渐降低,贮藏末期对照组降至0.97 kgf/cm2,较初始值下降54.26%,实验组硬度为1.41 kgf/cm2,较对照组高45.36%。这种差异表示抗菌处理能够延缓果实的软化过程,该现象可能是由于抗菌处理抑制了微生物的生长以及水分损耗,从而减缓了果实组织的降解。表明使用抗菌衬垫能够有效维持阳光玫瑰葡萄的硬度,延长口感保持时间以提高果实的食用价值。

图6 不同衬垫对阳光玫瑰葡萄贮藏期间硬度的影响
Fig.6 Effect of different liners on the firmness of Shine Muscat during storage
2.6 抗菌衬垫对阳光玫瑰葡萄贮藏期间TSS含量的影响
TSS含量可以反映出果实的成熟度和代谢状态,图7显示出,随着贮藏时间延长,TSS作为细胞呼吸作用的底物不断被消耗[25],整体呈现下降趋势。贮藏前2 d,对照组和实验组的TSS含量变化不大,且无显著差异。从第3天开始,对照组的TSS含量下降幅度增大,且实验组的TSS含量显著高于对照组。到第7天,实验组的TSS含量为17.17%,对照组为9.83%,较前者下降42.75%。实验组通过抗菌处理减少水分的流失,并减缓微生物的生长,从而减少微生物对可溶性糖的分解,维持较高的TSS含量。值得注意的是,在贮藏期间TSS含量出现短暂的回升,这可能是水分损耗和细胞呼吸强度之间出现的差异导致的。总的来说,抗菌处理对阳光玫瑰葡萄的TSS含量具有积极的调节作用,能够有效维持葡萄的品质。

图7 不同衬垫对阳光玫瑰葡萄贮藏期间TSS的影响
Fig.7 Effect of different liners on the total soluble solids of Shine Muscat during storage
2.7 抗菌衬垫对阳光玫瑰葡萄贮藏期间总酸含量的影响
TA含量是影响阳光玫瑰葡萄风味的一个重要指标,其变化直接决定了果实糖酸比与感官品质。图8表明,贮藏初期,对照组和实验组的TA含量无显著差异,两者均维持在较低水平并逐渐上升。从第3天开始,2组样品的总酸度出现显著差异,实验组的TA含量变化相对稳定,且在贮藏后期明显低于对照组。到第7天时,对照组TA含量升至21.78%,实验组为19.18%,较对照组低11.94%。该差异与细胞无氧呼吸产生乳酸等物质有关,抗菌处理通过减少微生物的活动以及延缓代谢过程维持阳光玫瑰葡萄的酸度水平,从而延缓其风味和品质的下降。数据说明,抗菌处理对稳定样品TA含量的效果较为显著,可以避免葡萄在短期内过酸而降低食用价值。

图8 不同衬垫对阳光玫瑰葡萄贮藏期间TA的影响
Fig.8 Effect of different liners on the tutritable aciditu of Shine Muscat during storage
3 结论与讨论
阳光玫瑰葡萄具有产销分离的典型特征,采用适当的抗菌包装可以有效地改善其贮藏品质。本研究旨在探讨添加百里香酚乳液的生物质泡沫衬垫,在模拟贮存条件下对阳光玫瑰葡萄生物安全性和品质的影响。研究结果显示,抗菌衬垫能够在发生跌落冲击、果实渗液等运输贮藏情况时对葡萄进行有效的防护,极端条件下坏果率保持在20%以下;研究发现添加百里香酚乳液对采后阳光玫瑰葡萄有明显的生理调节作用,使用抗菌衬垫能够有效抑制其在贮藏过程中的微生物生长,显著降低了葡萄果实的菌落总数,在贮藏第7天时仍保持在可食用范围内;通过抑制水分蒸发和细胞活动,稳定果实表面颜色、水分含量、TSS和有机酸含量,延缓了葡萄的褐变与腐烂进程,保持果实的色泽、重量、硬度、成熟度与风味,从而有效提高葡萄的贮藏品质。本研究中所用的抗菌剂由安全无毒的天然抗菌成分制备,泡沫衬垫为成本低廉、绿色环保的生物质材料。综上所述,利用Pickering理论赋予抗菌性的生物质泡沫衬垫在果蔬采后贮藏运输领域具有广阔的应用前景。
[1] 陈辰. 物流过程中鲜食葡萄品质的研究[D].天津:天津商业大学, 2016.
CHEN C.Study on quality of table grapes in the process of logistics[D].Tianjin:Tianjin University of Commerce, 2016.
[2] 麻明杰, 王梦琦, 杨义明, 等.葡萄研究进展与营养资源评价[J].现代农业研究, 2024, 30(10):17-22.
MA M J, WANG M Q, YANG Y M, et al.Advances in grape research and evaluation of nutritional resources[J].Modern Agriculture Research, 2024, 30(10):17-22.
[3] BAI L, LIU M H, SUN Y.Overview of food preservation and traceability technology in the smart cold chain system[J].Foods, 2023, 12(15):2881.
[4] 卞诚霞, 孟维坤, 苏冠勇, 等.食品包装塑料添加剂的暴露评估研究进展[J].江苏预防医学, 2024, 35(3):277-282.
BIAN C X, MENG W K, SU G Y, et al.Progress of researches on assessment of exposure to food packaging plastic additives[J].Jiangsu Journal of Preventive Medicine, 2024, 35(3):277-282.
[5] 向明月. 生鲜农产品冷链物流包装技术研究及应用[J].食品与机械, 2023, 39(8):103-109;141.
XIANG M Y.Research and application progress of cold-chain logistics packaging technology of fresh agricultural products[J].Food &Machinery, 2023, 39(8):103-109;141.
[6] XU W C, DONG L L.Influence of Antibacterial Packaging on Shelf Life of Fresh Grape[C].Proceedings of the 17th IAPRI World Conference on Packaging, 2010.
[7] CUI H Y, ABDEL-SAMIE M A, LIN L.Novel packaging systems in grape storage:A review[J].Journal of Food Process Engineering, 2019, 42(6):e13162.
[8] PIZZO J S, VISENTAINER J V, DA SILVA A L B R, et al.Application of essential oils as sanitizer alternatives on the postharvest washing of fresh produce[J].Food Chemistry, 2023, 407:135101.
[9] 吕明珠, 于爽, 朱恩俊.肉桂精油对红提葡萄保鲜效果的影响[J].食品科学, 2016, 37(6):272-277.
LYU M Z, YU S, ZHU E J.Efficacy of cinnamon essential oil for preservation of redglobe table grapes[J].Food Science, 2016, 37(6):272-277.
[10] 葛耀进. 抗奥氏熟化型百里香酚纳米乳液的构建、抗菌活性及微胶囊产品开发[D].南昌:南昌大学, 2024.
GE Y J.Construction, antibacterial activity and microcapsule product development of anti-Ostwald ripening thymol nanoemulsion[D].Nanchang:Nanchang University, 2024.
[11] PALOU E, L PEZ-MALO A, BARBOSA-C
PEZ-MALO A, BARBOSA-C NOVAS G V, et al.Polyphenoloxidase activity and color of blanched and high hydrostatic pressure treated banana puree[J].Journal of Food Science, 1999, 64(1):42-45.
NOVAS G V, et al.Polyphenoloxidase activity and color of blanched and high hydrostatic pressure treated banana puree[J].Journal of Food Science, 1999, 64(1):42-45.
[12] LANTE A, TINELLO F, NICOLETTO M.UV-a light treatment for controlling enzymatic browning of fresh-cut fruits[J].Innovative Food Science &Emerging Technologies, 2016, 34:141-147.
[13] 蔡名媛, 殷诚, 冯文一铭, 等.核黄素介导下光动力技术对鲜切梨品质的影响[J].食品与发酵工业, 2024, 50(19):299-305.
CAI M Y, YIN C, FENG W, et al.Effect of riboflavin-mediated photodynamic technology on fresh-cut pears quality[J].Food and Fermentation Industries, 2024, 50(19):299-305.
[14] 曹建康, 姜微波, 赵玉梅.果蔬采后生理生化实验指导[M].北京:中国轻工业出版社, 2007.
CAO J K, JIANG W B, ZHAO Y M.Physiological and Biochemi-cal Experiment Guidance of Postharvest Fruits and Vegetables[M]. Bejing:China Light Industry Press,2007.
[15] GAUCKLER L J, STUDART A R, TERVOORT E, et al.Ultrastable particle-stabilized foams and emulsions:U.S.Patent 8,975,301[P].2015-3-10.
[16] ABIDNEJAD R, BEAUMONT M, TARDY B L, et al.Superstable wet foams and lightweight solid composites from nanocellulose and hydrophobic particles[J].ACS Nano, 2021, 15(12):19712-19721.
[17] CERVIN N T, JOHANSSON E, LARSSON P A, et al.Strong, water-durable, and wet-resilient cellulose nanofibril-stabilized foams from oven drying[J].ACS Applied Materials &Interfaces, 2016, 8(18):11682-11689.
[18] HEE K, WON K, MOON H, et al.Sodium chloride significantly enhances the bactericidal actions of carvacrol and thymol against the halotolerant species Escherichia coli O157:H7, Listeria monocytogenes, and Staphylococcus aureus[J].LWT, 2020, 122:109015.
[19] SEPAHVAND S, AMIRI S, RADI M, et al.Antimicrobial activity of thymol and thymol-nanoemulsion against three food-borne pathogens inoculated in a sausage model[J].Food and Bioprocess Technology, 2021, 14(10):1936-1945.
[20] 徐敏敏, 王潮姿, 李文博, 等.百里香酚单向输水抑菌垫制备及其对冷鲜马肉保鲜研究[J].食品与发酵工业, 2024, 50(8):83-88.
XU M M, WANG C Z, LI W B, et al.Preparation of thymol one-way water delivery bacteriostatic pad and its study on preservation of cold fresh horse meat[J].Food and Fermentation Industries, 2024, 50(8):83-88.
[21] WU B, GU L Y, WANG W J, et al.Skin targeting of resveratrol-loaded starch-based Pickering emulsions:Preparation, characterization, and evaluation[J].Colloid and Polymer Science, 2021, 299(8):1383-1395.
[22] SU Q M, SU W T, XING S H, et al.Enhanced stability of anthocyanins by cyclodextrin-metal organic frameworks:Encapsulation mechanism and application as protecting agent for grape preservation[J].Carbohydrate Polymers, 2024, 326:121645.
[23] SWINNEN I A M, BERNAERTS K, DENS E J J, et al.Predictive modelling of the microbial lag phase:A review[J].International Journal of Food Microbiology, 2004, 94(2):137-159.
[24] NAVINA B, KESHAV HUTHAASH K, VELMURUGAN N K, et al.Insights into recent innovations in anti browning strategies for fruit and vegetable preservation[J].Trends in Food Science &Technology, 2023, 139:104128.
[25] ABDIPOUR M, SADAT MALEKHOSSINI P, HOSSEINIFARAHI M, et al.Integration of UV irradiation and chitosan coating:A powerful treatment for maintaining the postharvest quality of sweet cherry fruit[J].Scientia Horticulturae, 2020, 264:109197.